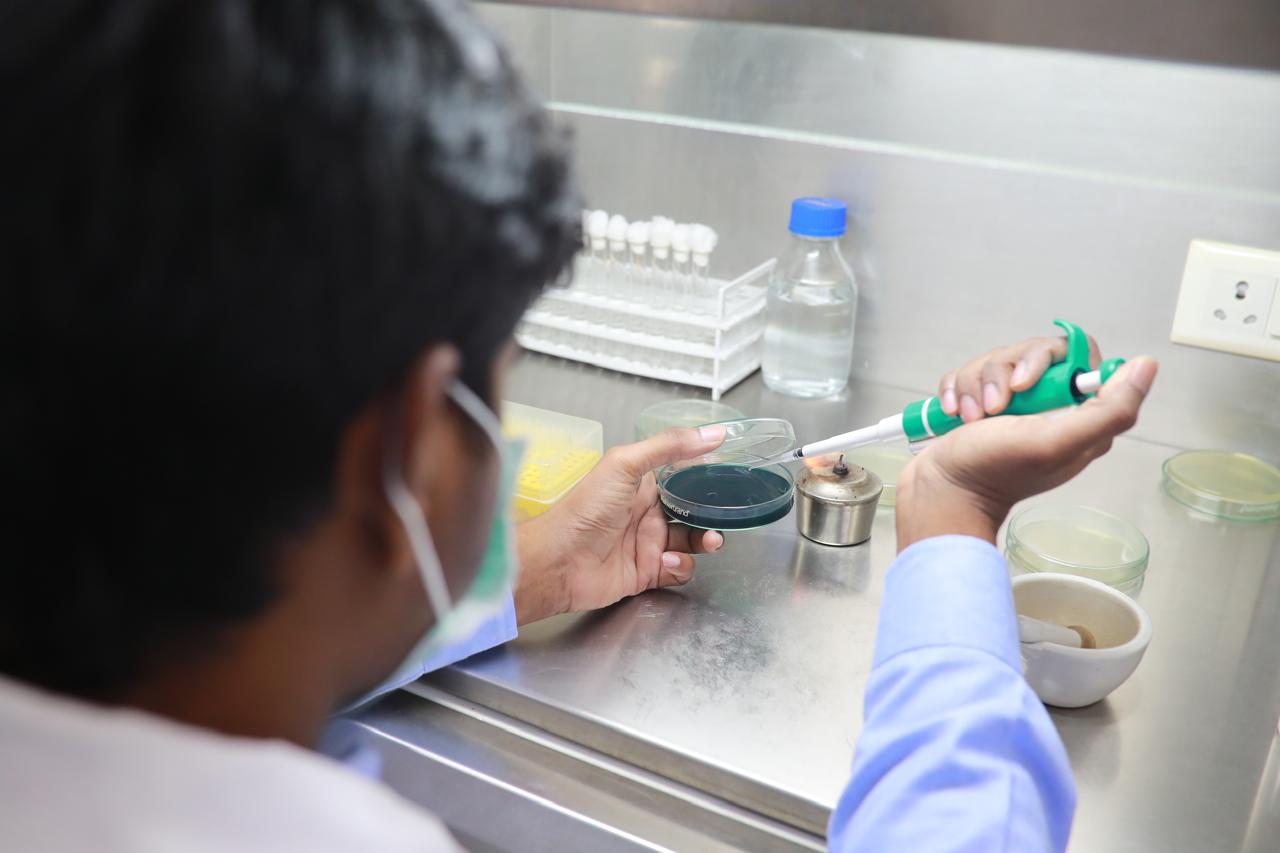

- Open Hours: Mon-Fri 8:00 am-6:00 pm
- Email: prasidhikaaa@gmail.com
- Address: 15/952, II Lane, Venkata Rama Puram, Nellore, 524002.
Health and Disease Management
- Home
- Health & Disease Management
Ask Question
Do You Need Any
Help?
- Call Us Now:
(+91) 9003150505
- Talk To Us:
prasidhikaaa@gmail.com

Health and Disease Management
we operate a world-class laboratory dedicated to ensuring the best possible shrimp seeds for farmers. Our lab combines advanced technology with skilled technicians who follow strict protocols to maintain the highest standards of quality and safety. Every shrimp seed undergoes a series of rigorous tests, and any batch that doesn’t meet our standards is discarded. This commitment to quality ensures that farmers receive only the healthiest and most reliable shrimp seeds for their farms.
Tests Conducted at Our Lab and Their Importance
We conduct various tests to guarantee the health of shrimp seeds and the quality of the environment they grow in. These tests are performed at regular intervals to ensure consistent quality and support farmers in achieving successful harvests.
1. Polymerase Chain Reaction (PCR) Testing
- Frequency: Conducted on every batch of shrimp seeds.
- Purpose: Identifies harmful pathogens such as:
- White Spot Syndrome Virus (WSSV)
- Infectious Hypodermal and Hematopoietic Necrosis Virus (IHHNV)
- Yellow Head Virus (YHV)
- Taura Syndrome Virus (TSV)
- Acute Hepatopancreatic Necrosis Disease (AHPND)
- Farmer Benefit: Ensures disease-free shrimp seeds, reducing the risk of infections spreading in their farms and increasing survival rates.
2. Histopathology Testing
- Frequency: Performed periodically on sampled batches.
- Purpose: Examines shrimp tissue at the cellular level to detect any hidden infections or abnormalities in organs like the hepatopancreas.
- Farmer Benefit: Helps prevent undetected diseases, ensuring only healthy and strong shrimp seeds are supplied to farmers.

3. Stress Testing
- Frequency: Conducted on every batch before delivery.
- Purpose: Tests the shrimp seeds under stressful conditions (e.g., changes in water temperature and quality) to ensure they can handle environmental challenges.
- Farmer Benefit: Guarantees that the seeds are robust and adaptable, improving survival and growth rates even in variable farming conditions.
4. Microbiology Testing
- Frequency: Performed weekly or as needed.
- Purpose: Monitors microbial loads to detect harmful bacteria, like Vibrio species, which can cause infections.
- Farmer Benefit: Maintains clean and healthy hatchery conditions, protecting the seeds from bacterial diseases.
5. Water Quality Monitoring
- Frequency: Daily checks in hatchery tanks.
- Purpose: Analyzes water parameters such as:
- Ammonia and nitrite levels
- Salinity and pH
- Heavy metal contamination
- Farmer Benefit: Ensures shrimp are raised in a healthy environment, leading to strong and disease-free seeds.
6. Genetic Testing
- Frequency: Conducted periodically on broodstock and larvae.
- Purpose: Assesses genetic traits to ensure the production of shrimp that are fast-growing, disease-resistant, and well-suited for farming.
- Farmer Benefit: Provides farmers with shrimp seeds that are not only healthy but also deliver better yields and profitability.
7. Environmental Testing
- Frequency: Regularly, in and around hatchery facilities.
- Purpose: Evaluates water and soil quality in larval rearing tanks and surrounding areas.
- Farmer Benefit: Protects the shrimp from environmental contamination, ensuring a safe start to their growth.
How These Tests Help Farmers
1.Disease Prevention
Early detection of diseases ensures that farmers receive seeds that won’t cause disease outbreaks in their ponds, saving time, money, and effort.
2.Improved Survival Rates
Healthy, stress-tested seeds have a higher chance of surviving and thriving, even in challenging environments.
3.Higher Yields
Disease-free and genetically superior shrimp seeds grow faster and stronger, giving farmers better harvests and increased profits.
4.Environmental Safety
By monitoring water quality and controlling microbial loads, we ensure a clean and safe environment for shrimp farming, reducing risks of contamination.
5.Trust and Transparency
Farmers receive detailed reports of the tests conducted, giving them confidence in the quality of the shrimp seeds they are purchasing.
6.Consistent Quality
Regular and rigorous testing ensures that farmers get the same high-quality product every time.
Subscribe To Our Newsletter

At Prasidhi imports and exports, we are dedicated to providing top-tier services to shrimp farmers, ensuring optimal growth, health, and profitability of your shrimp farming operations.
Working Hours
Mon – Fri: 9:00AM – 6:00PM
Sat – Sun: 8:00AM – 4:00PM
Copyright 2025 Prasidhiimpex Design and developed by Team LetzBizz – All Rights Reserved.
